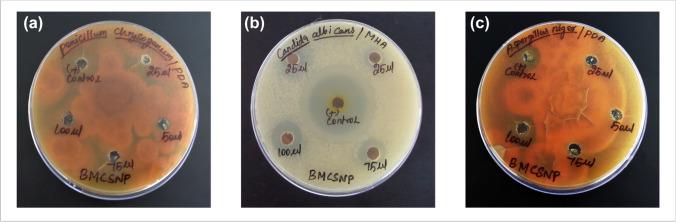

桑色素共轭硒纳米颗粒的药理学前景——抗菌、抗氧化、溶栓及抗癌活性评估
Pharmacological Prospects of Morin Conjugated Selenium Nanoparticles-Evaluation of Antimicrobial, Antioxidant, Thrombolytic, and Anticancer Activities.
作者信息
Nirmala C, Sridevi M, Aishwarya A, Perara Richard, Sathiyanarayanan Y
机构信息
Department of Biotechnology, Paavai Engineering College, Paavai Institutions, Namakkal, Tamilnadu India.
Department of Biotechnology, Vinayaka Mission's Kirupananda Variyar Engineering College, Vinayaka Mission's Research Foundation (Deemed to be University), Salem, Tamilnadu India.
出版信息
Bionanoscience. 2023 May 9:1-14. doi: 10.1007/s12668-023-01116-y.
ABSTRACT
Selenium nanoparticles (SeNPs) have gained wide importance in the scientific community and have emerged as an optimistic therapeutic carrier agent for targeted drug delivery. In the present study, the effectiveness of nano selenium conjugated with Morin (Ba-SeNp-Mo) produced from endophytic bacteria reported in our earlier research was tested against various Gram-positive, Gram-negative bacterial pathogens and fungal pathogens that showed good zone of inhibition against all selected pathogens. Antioxidant activities of these NPs were studied by 1, 1-diphenyl-2- picrylhydrazyl (DPPH), 2,2'-Azino-bis-3-ethylbenzothiozoline-6-sulfonic acid (ABTS), hydrogen peroxide (HO), superoxide (O), and nitric oxide (NO) radical scavenging assays that exhibited dose-dependent free radical scavenging activity with IC values 6.92 ± 1.0, 16.85 ± 1.39, 31.60 ± 1.36, 18.87 ± 1.46, and 6.95 ± 1.27 μg/mL. The efficiency of DNA cleavage and thrombolytic activity of Ba-SeNp-Mo were also studied. The antiproliferative effect of Ba-SeNp-Mo was determined by 3-(4,5-dimethylthiazol-2-yl)-2,5-diphenyltetrazolium bromide (MTT) assay in COLON-26 cell lines that resulted in IC value of 63.11 μg/mL. Further increased intracellular reactive oxygen species (ROS) levels up to 2.03 and significant early, late and necrotic cells were also observed in AO/EtBr assay. CASPASE 3 expression was upregulated to 1.22 (40 μg/mL) and 1.85 (80 μg/mL) fold. Thus, the current investigation suggested that the Ba-SeNp-Mo has offered remarkable pharmacological activity.
摘要
硒纳米颗粒(SeNPs)在科学界已变得极为重要,并已成为一种用于靶向药物递送的理想治疗载体。在本研究中,测试了我们早期研究中报道的由内生细菌产生的与桑色素共轭的纳米硒(Ba-SeNp-Mo)对各种革兰氏阳性、革兰氏阴性细菌病原体和真菌病原体的有效性,其对所有选定病原体均显示出良好的抑菌圈。通过1,1-二苯基-2-苦基肼(DPPH)、2,2'-偶氮二(3-乙基苯并噻唑啉-6-磺酸)(ABTS)、过氧化氢(HO)、超氧阴离子(O)和一氧化氮(NO)自由基清除试验研究了这些纳米颗粒的抗氧化活性,这些试验显示出剂量依赖性的自由基清除活性,IC值分别为6.92±1.0、16.85±1.39、31.60±1.36、18.87±1.46和6.95±1.27μg/mL。还研究了Ba-SeNp-Mo的DNA切割效率和溶栓活性。通过在COLON-26细胞系中进行的3-(4,5-二甲基噻唑-2-基)-2,5-二苯基四氮唑溴盐(MTT)试验测定了Ba-SeNp-Mo的抗增殖作用,其IC值为63.11μg/mL。在吖啶橙/溴化乙锭(AO/EtBr)试验中还观察到细胞内活性氧(ROS)水平进一步升高至2.03,并且出现了显著的早期、晚期和坏死细胞。半胱天冬酶3(CASPASE 3)表达上调至1.22倍(40μg/mL)和1.85倍(80μg/mL)。因此,目前的研究表明Ba-SeNp-Mo具有显著的药理活性。